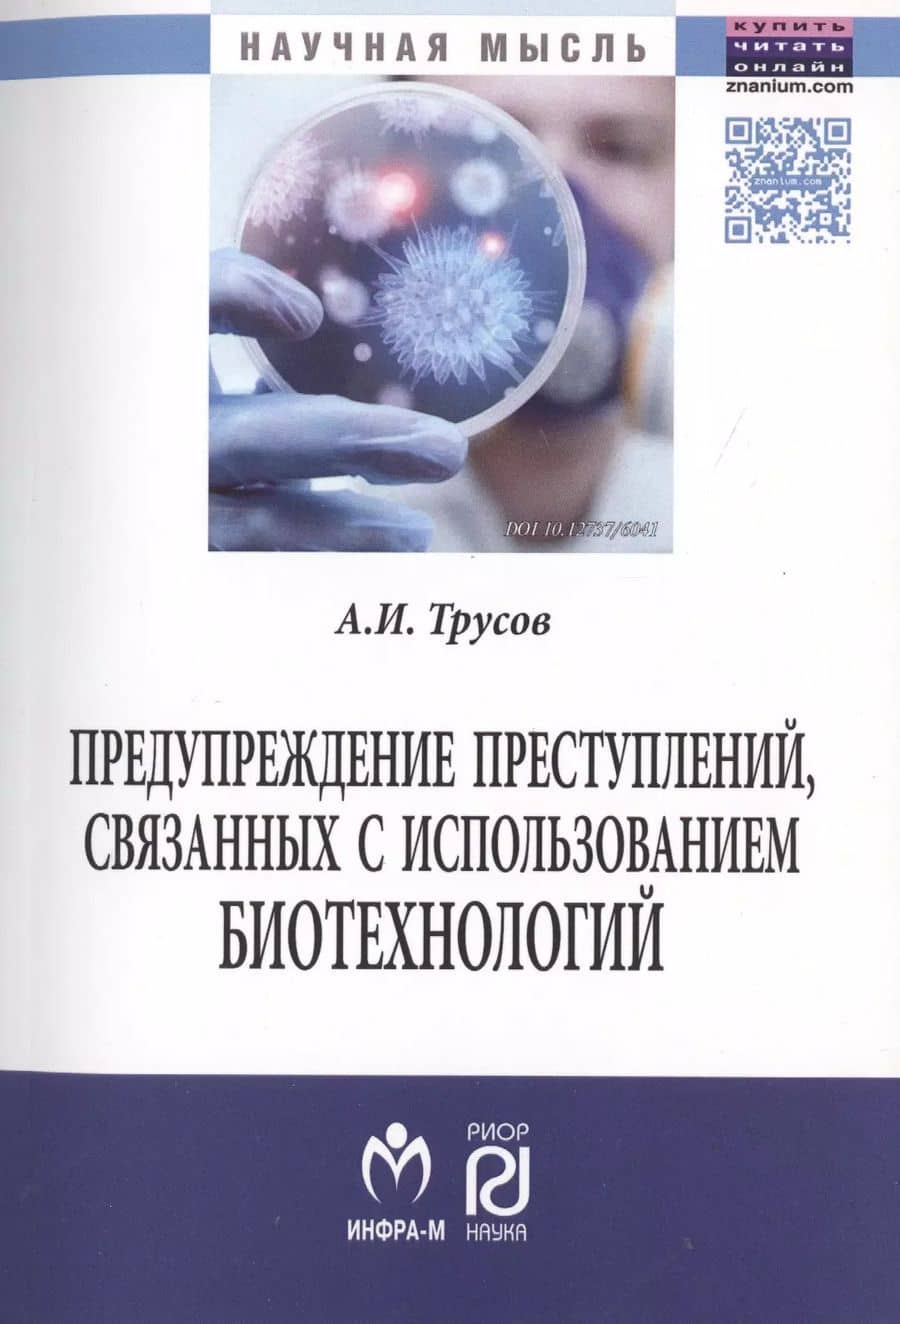

Предупреждение преступлений, связанных с использованием биотехнологий.

Биотехнологическая революция предоставила широкие возможности гуманистического использования результатов открытий. Однако всредне-срочной перспективе следует ожидать появления совершенно новых для России преступлений, связанных с нелегальным использованием современных биотехнологий.. .Монография рассчитана на курсантов, студентов, адъюнктов, аспирантов, соискателей, занимающихся исследованиями в данных областях. Также может быть использована преподавателями и научными сотрудниками вузов..
Go to description and details| Publisher | РИОР |
| Publication year | 2017 |
| ISBN | 978-5-369-01420-2 |
| Weight, g | 237 |
Биотехнологическая революция предоставила широкие возможности гуманистического использования результатов открытий. Однако всредне-срочной перспективе следует ожидать появления совершенно новых для России преступлений, связанных с нелегальным использованием современных биотехнологий.. .Монография рассчитана на курсантов, студентов, адъюнктов, аспирантов, соискателей, занимающихся исследованиями в данных областях. Также может быть использована преподавателями и научными сотрудниками вузов..
| Publisher | РИОР |
| Publication year | 2017 |
| ISBN | 978-5-369-01420-2 |
| Weight, g | 237 |